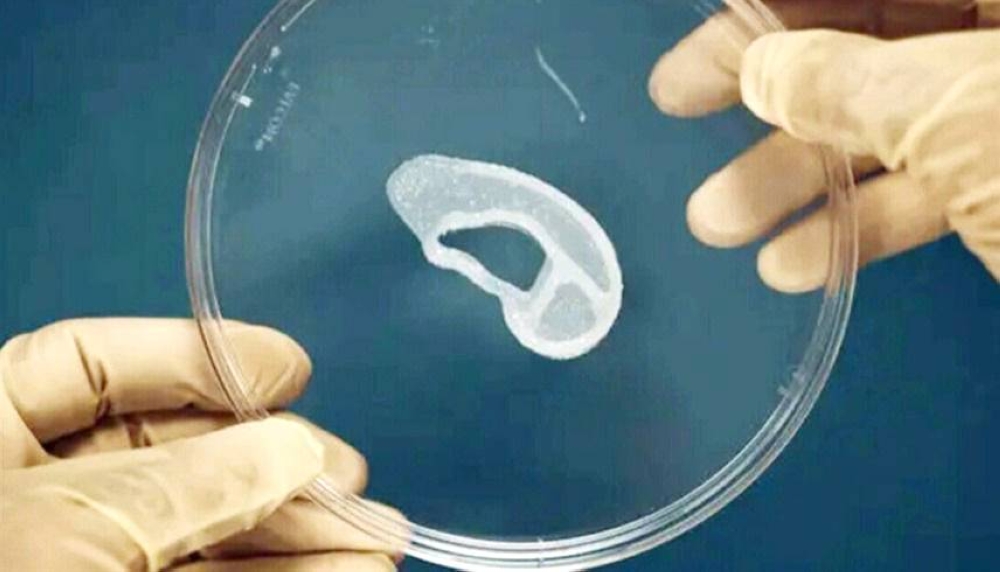

ابتكر علماء آذاناً خارجية بديلة مصنوعة في المختبر للأشخاص الذين تشوهت آذانهم عند الولادة أو بسبب الإصابة، وإنهم أصبحوا قريبين من إتقان عمل أذن بشرية تشعر وتقاوم الإصابة مثل الأذن الحقيقية.
ووفق «هيلث داي»، فإن من شأن مثل هذا التقدم أن يفيد بشكل كبير الذين يعانون من تشوّه الأذن الخِلْقي منذ الولادة، أو من فقدوا آذانهم أو تضررت بسبب الإصابة.
